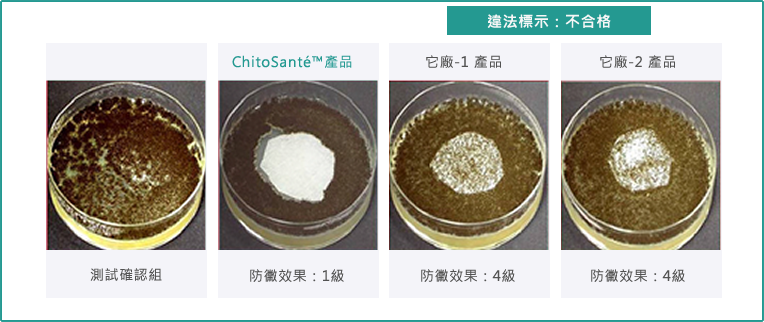

ChitoSanté™ 加工劑 : 通過美國USP <51>測試
ChitoSanté™ 加工劑─天然、無毒、安全產品
- 天然、無毒:經口致死量LD50 =16 g/kg【0級—無毒性】
衛生、健康:完全能夠讓您放心使用
安全、無毒:通過美國F.D.A.安全認證 - 天然成份鑒定中心:100%─天然材料
通過:美國 USP<51> 測試:抑菌、淨味
抑菌:99.9% 防黴:1級
能有效防止ChitoSanté™の 濕紙巾不發霉、不變味

方法:USP <51>:美國防腐/抗菌劑效力测试(Antimicrobial Effectiveness Test)
目的:為防止材料在保存過程中或使用過程中發生微生物腐败現象,须在材料中加入適量的防腐劑,防腐剂效果如何,则需通過USP《51》测試進行評價。
評估項目:
ChitoSanté™ 加工劑,通過美國USP <51>測試 :
USP<51>测試簡述: 將標準指定编号的以下菌株接入樣品,然后在第7 天,第14 天,第28 天分别檢驗每種菌的存活数量,存活數量越少,其防腐劑抗菌效果越好。
細菌:
細菌:
Escherichia coli 大腸桿菌
Pseudomonas aeruginosa 綠膿桿菌
Staphylococcus aureus 金黄色葡萄球菌
真菌:Candida albicans 白色念珠菌
Aspergillus niger 黑曲黴菌

實驗結果:【 ChitoSanté™ 工作液 】特性-1:抗菌效果


實驗結果:【 不含ChitoSanté™工作液 】特性-1:抗菌效果

實驗結果:【 不含ChitoSanté™工作液 】特性-1:抗菌效果

市售產品:USP <51> 防黴測試:比較